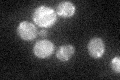
YJR019C
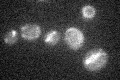
YJR019C

View description
Peroxisomal acyl-CoA thioesterase likely to be involved in fatty acid oxidation rather than fatty acid synthesis; conserved protein also found in human peroxisomes; TES1 mRNA levels increase during growth on fatty acids
Localization:
Intensity:
Fold change:
Significance:
-
C’ GFP library in SD
mitochondria24.09 -
N' NOP1pr-GFP in SD

punctate59.0677 -
N' TEF2pr-mCherry in SD

punctate83.7994 -
N' NATIVEpr-GFP in SD

punctate30.2753 -
N' TEF2pr-VC and Cyto-VN in SD

punctate26.6381 -
C’ GFP library in SD+DTT

mitochondriaN/AN/ANo -
C’ GFP library in SD+H2O2
mitochondria18.010.74Yes -
C’ GFP library in Starvation Media

mitochondria31.91.32Yes -
C’ GFP library on the background of Pup2-DaMP

mitochondria -
C’ GFP library on the background of CCT mutant

mitochondria21.93710.910549No
